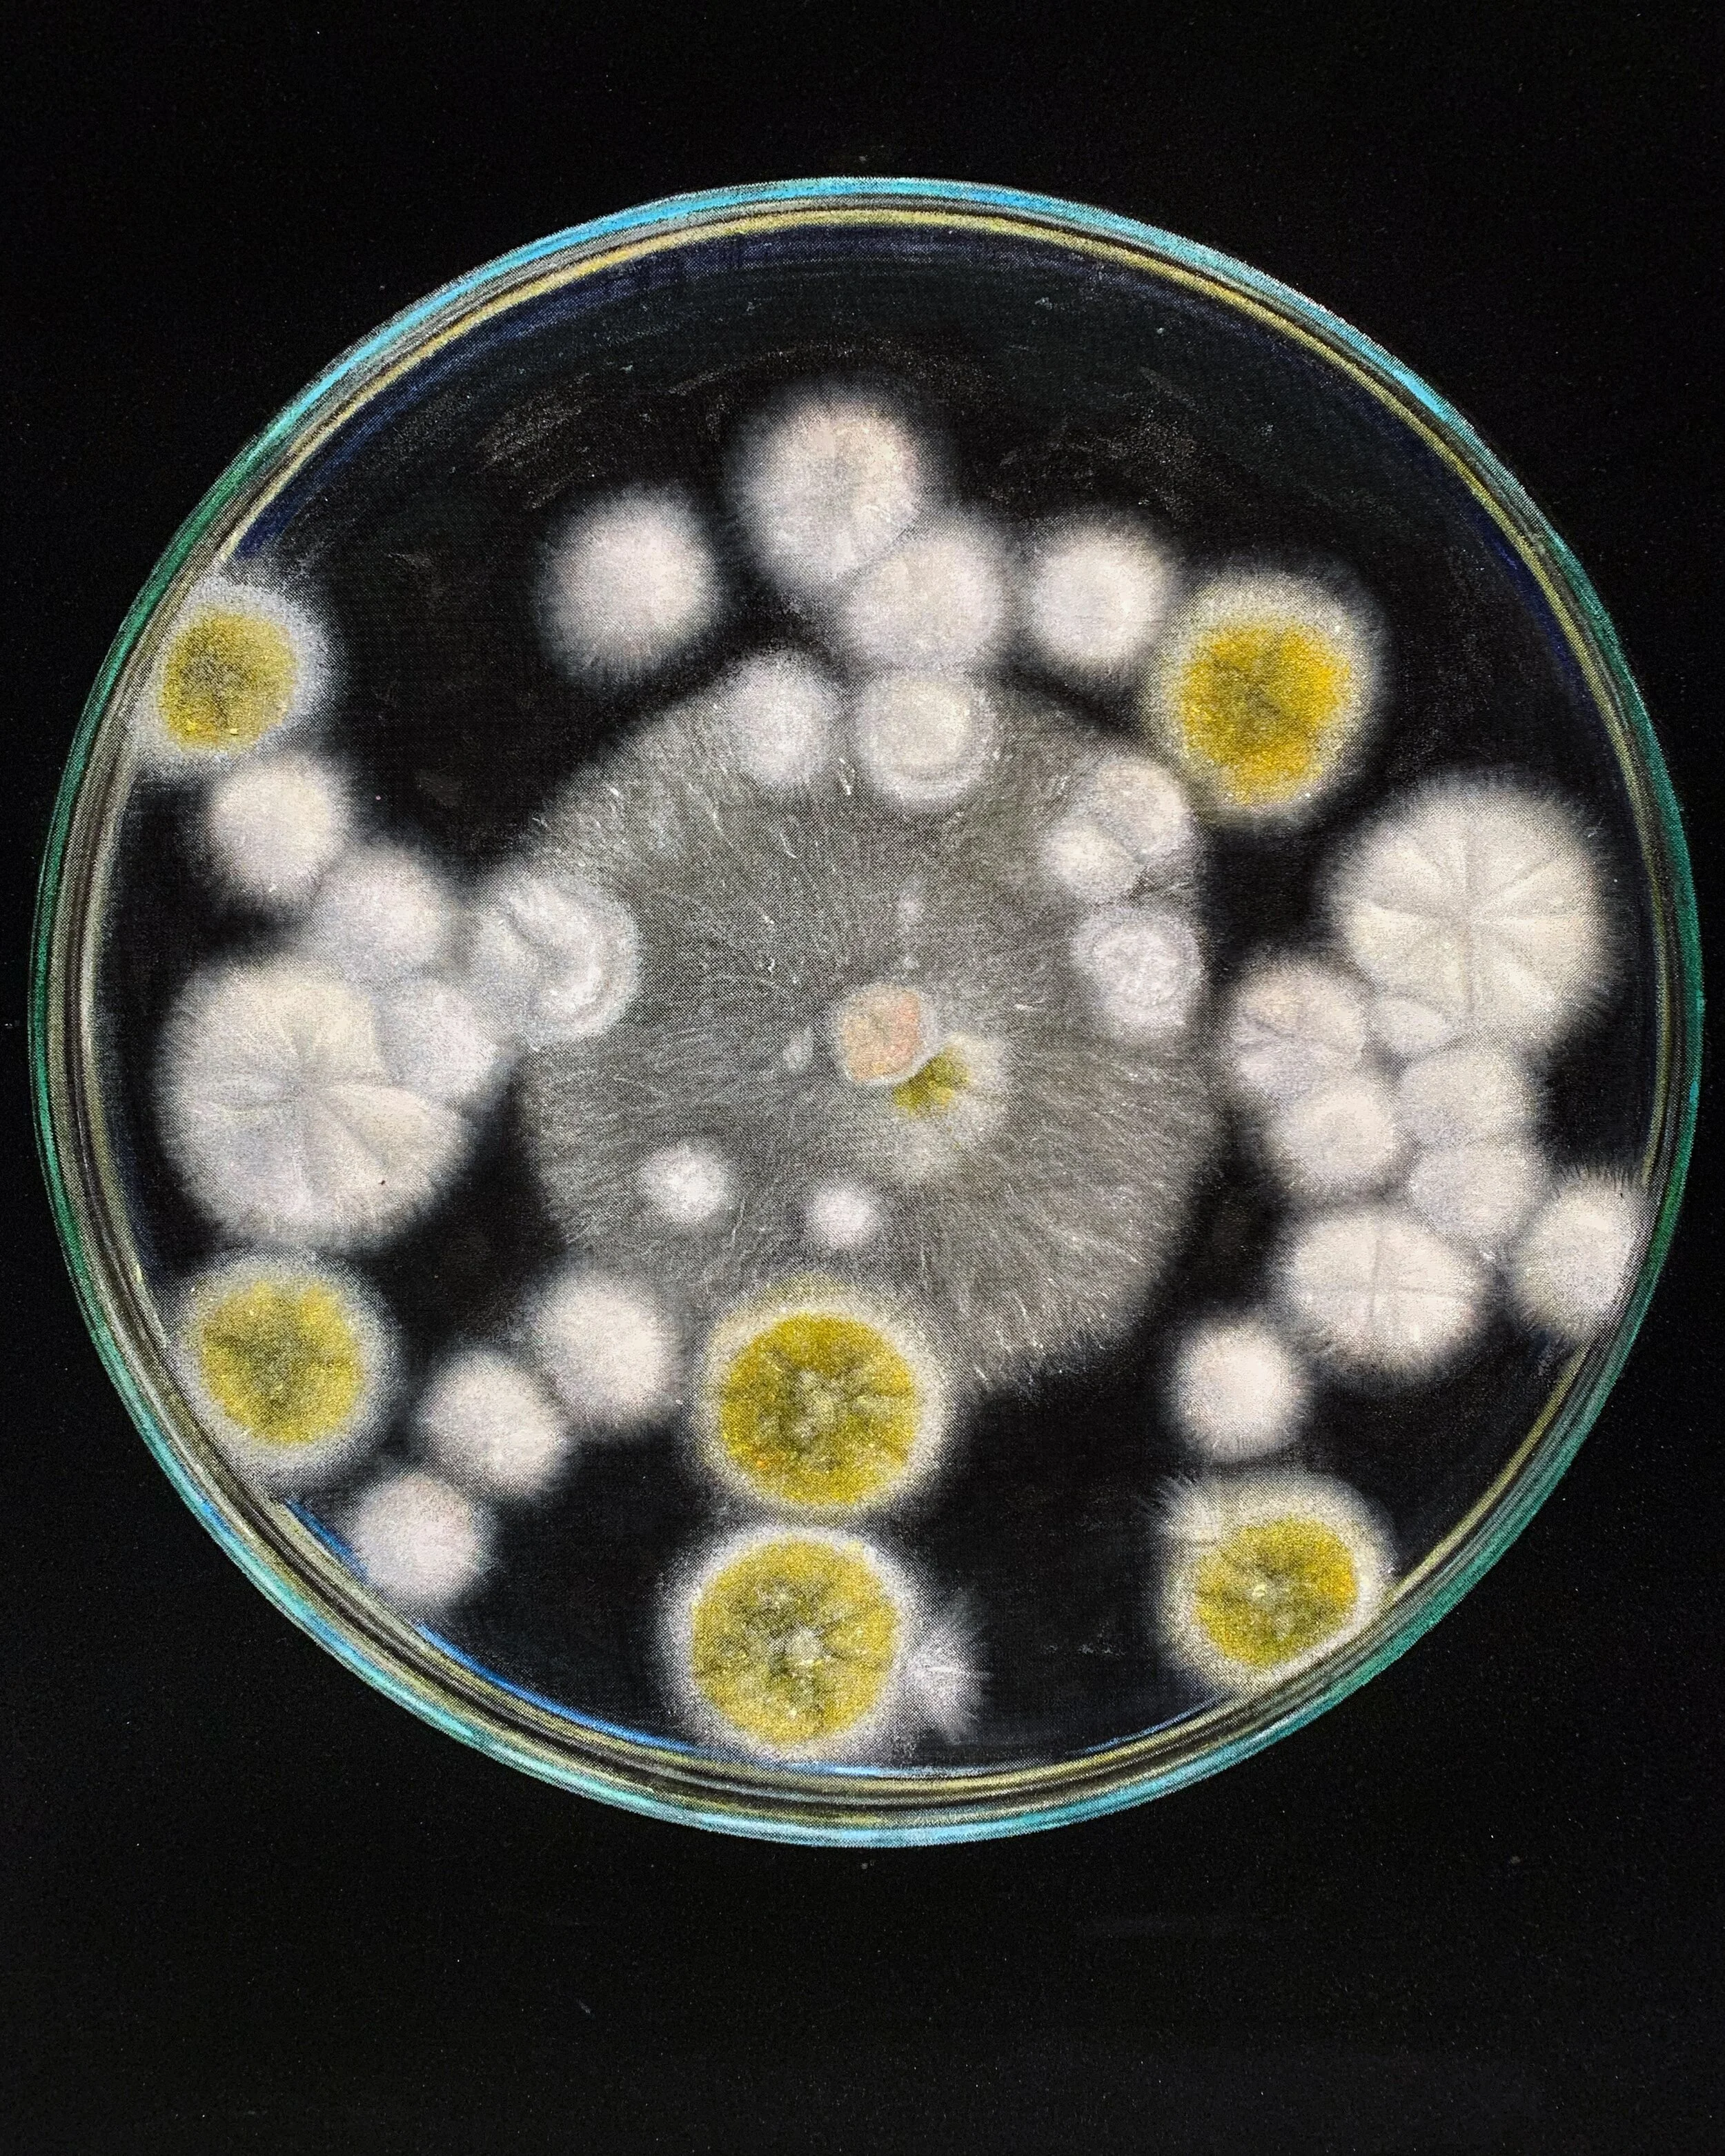
Duo exhibition “A Cow's Head And a Horse's Jaw” at Karin Weber Gallery

Saskia Saunders: Sanctuary at Contemporary Crafts Centre
Simultaneously airy and physical, delicate and textural, soothing and tempting — well, last one could be my personal peculiar feature: I love touching woven objects (but don’t worry, I didn’t).
Exhibition period: 2–25.07.21
Gallery address: Hollywood Building, Sheung Wan